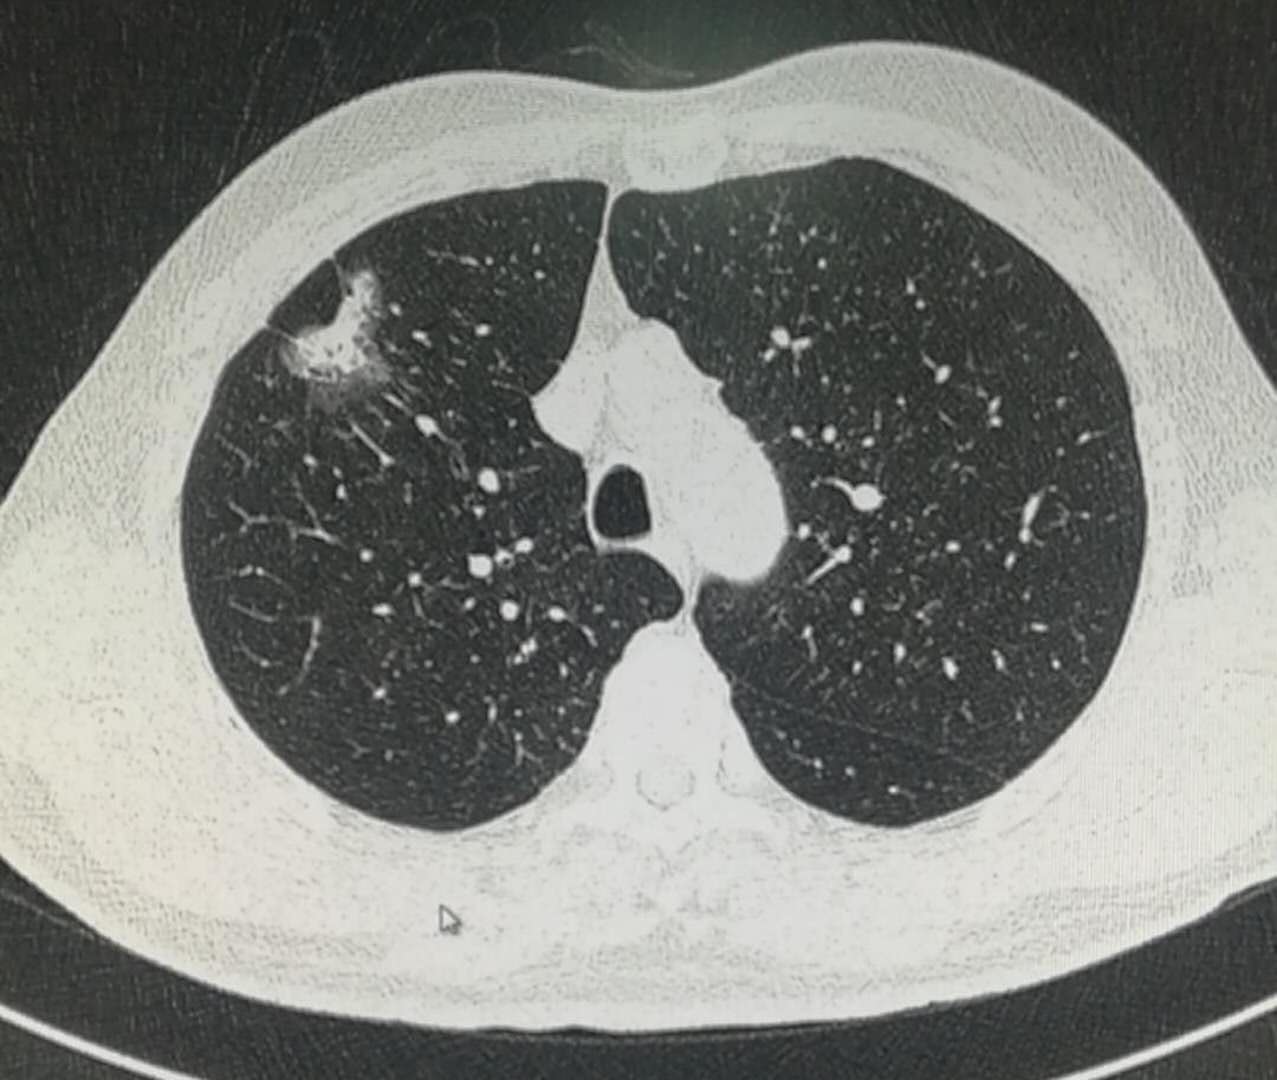
磨玻璃肺结节手术后需要化疗吗,2.5厘米肺结节微创手术后要化疗吗

现在肺癌发病率真是很高,我们科室每天至少要诊断2例,占全部病例的1%以上。
肺癌早期症状不典型,并且40岁以下的年轻人也不再罕见。
曾经有位30多岁的女子,摸到脖子上有个硬结,结果进一步发现了肺癌,颈部淋巴结转移;
但随着健康体检观念的普及,更多的肺癌患者得以及时发现及时治疗,延长了寿命。
今天这位老爷子就是比较幸运的!
老人年轻时候拉扯孩子不容易,靠着几亩地刨吃食,饱经风霜脸色黝黑,不过精气神很好,一身很朴实的打扮!
今天是因为孩子们大了,生活条件好了,又孝顺,非要带老两口来做个体检。
孩子的孝心有时可以续命
老爷子身板硬朗,没有任何不适症状,但是肺部CT发现了磨玻璃结节:

这个病灶位于右上肺叶,边界清晰,在磨纱玻璃密度内部还可以看到白色的实性密度区,所以属于混合磨玻璃密度结节;
同时还可以看到线样的胸膜牵拉:

这个肺结节会是肺癌吗?
发现了肺部病灶,一般要分三个步骤:
先确定肿瘤还是非肿瘤,再确定良恶性,之后是判定小细胞肺癌还是非小细胞(治疗原则不同)。
阅读过豪大夫肺结节系列的读者朋友,可能就会想到一个诊断要点:混合磨玻璃结节伴有胸膜牵拉,符合肺腺癌。
所以这是一个肿瘤性病变,恶性,符合肺腺癌(不符合小细胞肺癌)。
那么,这位老人该怎么治疗呢?能做手术吗?
关于治疗角度的知识点:
影像可以判定某些肺癌的预后,据文献报道:磨玻璃结节直径<2厘米且实性成分<50%的肺癌,很少含有预后不良的病理亚型(微乳头和实性成分)。换句话说,如果磨玻璃病灶小于2厘米,并且白色实性部分小于一半,治疗效果极好。
那么,这位老人的病灶属于这种类型吗?
很遗憾,不属于,他的病灶接近3厘米了,并且伴有较多实性成分和胸膜牵拉。
据统计,这种线样的胸膜牵拉,侵犯胸膜的几率大约是20%。
诊断混合性磨玻璃结节侵犯胸膜的依据:
同时具备:病灶与胸膜相贴,直径大于2厘米,实性成分大于50%,局部胸膜增厚,则胸膜受侵的几率为99.2%。
如果上面4条都不具备,则胸膜受侵的可能性接近于0。
而如果发生了胸膜侵犯,就不推荐亚肺叶切除了,需要扩大切除范围。
依据上面这些知识点,我们判定老人是肺腺癌,存在胸膜侵犯的风险,建议及时手术治疗,并且要根据术后病理类型和胸膜是否侵犯,确定是否采取术后化疗降低复发。
如果病理显示病灶内有微乳头或者实体性生长成分(低分化),术后化疗是有意义的,可以降低复发几率。
但总的来说,老人的肺肿瘤发现得还不晚,虽然他还没有出现咳嗽咳血等肺部症状。
反过来想,如果不是孩子们尽孝,拉着老人来做体检,再拖一段时间后果就难以预料了,毕竟病灶已经存在胸膜牵拉了。
中华民族是个讲究孝道的民族,很多时候孝心可以规避瘟神,悄悄给老人续命。
在医院待久了,有时候真的会相信因果,相信好人有好报!
这里是影像科豪大夫,感谢您的阅读,欢迎关注豪大夫肺结节系列文章。